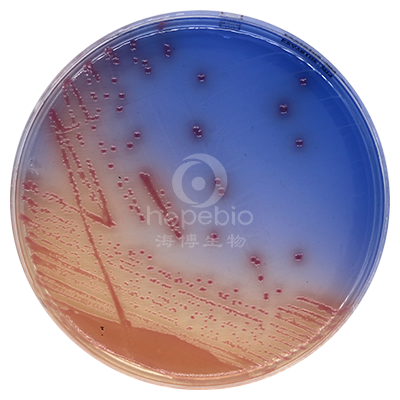
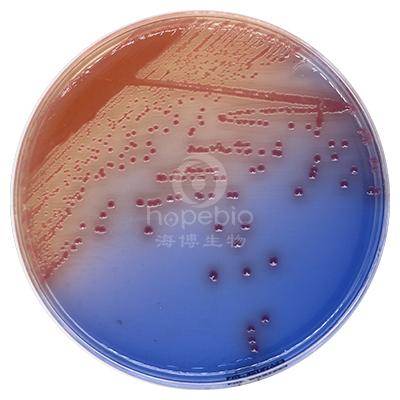

海博微信公众号
海博微信公众号
 海博天猫旗舰店
海博天猫旗舰店


 海博微信公众号
海博微信公众号
 海博天猫旗舰店
海博天猫旗舰店



多达600种微生物培养基配方、原理、用法、质量控制,涵盖所有常检细菌及其他细菌,涉及食品卫生检验、医药、水质、临床、化妆品等各个领域、为您提供最详尽的微生物培养基相关知识。



应用范围:大肠杆菌O157:H7显色培养基是青岛海博生物公司改良的培养基,用于食品、病人粪便样品中O157:H7菌的快速检测。O157:H7菌显亮红色、淡红色或红色,菌落周围没有蓝色晕圈,大肠杆菌和大肠菌群显暗蓝色、蓝色或紫色,菌落周围有蓝色晕圈;其它细菌显蓝色、黄色或无色。本培养基的特异性高,可以克服SMAC培养基引起的假阳性和假阴性结果,是一种很理想的快速检测培养基。
| 特殊营养物质 | 68.4 |
| 混合显色剂 | 2.6 |
| 琼脂 | 15.0 |
| pH7.0±0.1 25℃ | |
|
质控菌株 |
ATCC |
生长情况 |
菌落颜色 |
|
大肠杆菌O157 |
35150 |
+++ |
亮红色 |
|
金黄色葡萄球菌 |
25923 |
-/+ |
黄色或无色 |
|
大肠杆菌 |
25922 |
+/- |
暗蓝色,菌落周围有蓝色晕圈 |
|
沙门氏菌 |
14028 |
+++ |
蓝色 |
|
奇异变形杆菌 |
12453 |
+/- |
无色 |
|
肺炎克雷伯氏菌 |
10031 |
+/- |
蓝色,菌落周围有蓝色晕圈 |
|
弗氏柠檬酸盐杆菌 |
43864 |
+/- |
蓝色菌落有紫色中心,菌落周围有蓝色晕圈 |
|
阪崎杆菌 |
29004 |
++ |
紫色至蓝色 |
方法的局限性:
本培养基上的典型大肠杆菌O157:H7必须做血清学试验或生化试验。
典型特征:
典型大肠杆菌O157:H7菌显亮红色、淡红色或红色,菌落周围没有蓝色晕圈;大肠杆菌和大肠菌群显蓝色或紫色,菌落周围有蓝色晕圈;其它细菌显蓝色、黄色或无色;
|
|
|
O157显色培养基 大肠埃希氏菌O157:H7 ATCC35150 |
O157显色培养基 大肠埃希氏菌O157:H7 ATCC43888 |
贮存:
制备好的平板可保存 2-5 天,应避免光线直接照射。干燥培养基应放置于阴暗干燥处, 保存温度 2-8℃,注意避光保存。
失效:
干燥培养基超过保质期、结块和颜色变化都不能使用。
注意:
此培养基仅供实验室使用。
参考文献:
1、Rappaport, F., and E. Henig. 1952. Media for the isolation and differentiation of pathogenic Escherichia coli (serotypes 0111 and 055). J. Clin. Pathol. 5:361-362.
2、 U.S. Food and Drug Administration. 1995. Bacteriological analytical manual, 8 th ed., AOAC International, Gaithersburg, MD.
点击下方链接查看更多产品详情(用法、原理、产品图片、微生物生长特征等)
 O157显色培养基相关产品配方:
O157显色培养基相关产品配方:|
产品货号 |
查看配方 |
产品说明及用途 |
查看产品详情 |
|
HB4088
|
三糖铁(TSI)琼脂 |
生化培养基,用于肠杆菌科细菌的生化反应筛选(GB2008标准)
|
|
|
HB0146-1
|
月桂基硫酸盐胰蛋白胨MUG培养基 |
用于O157菌检测,已含MUG
|
|
|
HB0147
|
mEC肉汤 |
用于0157选择性增菌(USDA-FSIS方法)
|
|
|
HB0148
|
mTSB肉汤 |
用于0157选择性增菌(ISO方法)
|
|
|
HB0121-3
|
改良山梨醇麦康凯(CT-SMAC)琼脂 |
用于大肠杆菌O157的分离培养(GB2008)标准
|
|
|
HB0147-1
|
改良EC肉汤(mEC+n) |
用于0157选择性增菌(GB2008标准)
|
|
|
HB4168
|
半固体琼脂 |
用于O血清不凝集时,细菌抗原的准备培养
|
|
|
HB0121
|
山梨醇麦康凯琼脂基础(SMAC) |
用于大肠杆菌O157的分离培养
|
|
|
HB8659
|
改良麦康凯肉汤(CT-MAC) |
用于O157选择性增菌培养
|
|
|
HB0416-1
|
月桂基硫酸盐蛋白胨肉汤-MUG |
用于O157菌检测,(GB2008标准)
|



